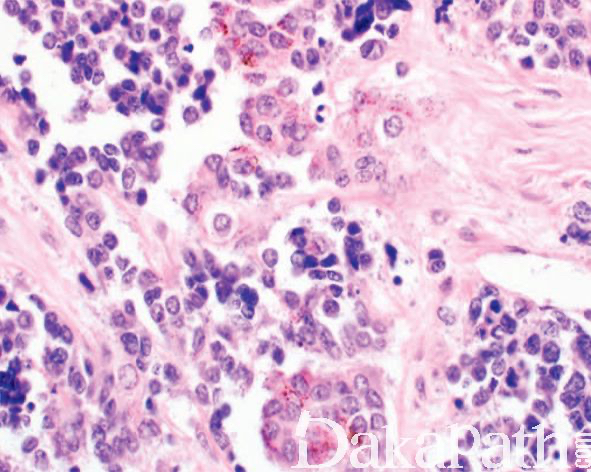

婴儿色素性神经外胚层瘤
Melanotic Neuroectodermal tumor of Infancy
同义词(或曾用名): 视网膜始基瘤、色素性突变瘤、色素性成釉细胞瘤
概述:
是一种黑色素性神经上皮瘤,主要发生在婴幼儿的颌骨部位,由神经母细胞性小圆细胞和含色素的上皮性大细胞组成。
发病部位: 上颌骨、下颌骨、颅骨、附睾、颅脑硬膜、眼眶、颊部、纵隔、大脑、子宫、卵巢、长骨及肩胛等处。
诊断要点:
好发于 1 岁以下的婴幼儿,主要发生于上颌骨、下颌骨、颅骨,其它部位包括中枢神经系统,睾丸,卵巢和皮下软组织等,大体表现为呈界限清楚无包膜的分叶状肿块;
镜下主要可见 2 种细胞,神经母细胞样细胞和上皮性细胞;
神经母细胞样细胞为小的圆形或小立方,核深染、固缩状,多呈巢状或假腺泡状排列;有时该类细胞之间可见神经纤维网样物质;
上皮性细胞体积大,胞质含色素,核呈空泡状,核分裂像罕见,围绕巢状或假腺泡状结构周围;
细胞巢之间可见致密的纤维结缔组织,位于颅面部的肿瘤常可见到骨小梁浸润;
有些病例假腺泡状结构不明显,主要由不规则片状、巢状或梁束状的色素性上皮细胞组成;
少数病例主要由呈挤压状的管状结构组成,仅含有很少的小圆细胞。

免疫组织化学染色:
上皮性细胞表达 CK、EMA、HMB45. vimentin、NSE 和 Leu 7;小圆细胞表达 NSE 和 Leu 7,部分病例表达 SYN、GFAP 和 S-100,罕见表达 NFP 和 CD99。
鉴别诊断:
1. 转移性神经母细胞瘤 :肿瘤内富含神经纤维网,可见菊形团结构,极少有色素。
2. 恶性黑色素瘤 :瘤细胞具明显的异型性,核分裂像多见,免疫组织化学染色 CK 及 EMA 阴性。
3. 胚胎性横纹肌肉瘤 :很少含有色素,间质常呈疏松黏液样;免疫组织化学染色 desmin 及 myogenin 等肌源性标记阳性,CK、HMB45 及 NSE 阴性。
预后:
通常为良性,多中心性生长而切除不完整者可出现局部复发,复发率可达 15%-27%,以神经母细胞样成分为主者较易出现复发。恶变率约 6.5%,提示恶性转化的组织学证据包括:≥2 个核分裂像/10HPF;Ki67 > 25%,免疫组化染色表达 CD99 等。转移率约 3%,主要发生于区域淋巴结和中枢神经系统。
治疗:
肿瘤完整切除。术后放化疗的作用还不十分清楚。
病例报道:
Kruse-L¨ osler B, Gaertner C, B¨ urger H, Seper L, Joos U, Kleinheinz J. Melanotic neuroectodermal tumor of infancy: systematic review of the literature and presentation of a case. Oral Surg Oral Med Oral Pathol Oral Radiol Endod. 2006;102(2):204–216. 参考文献:
Kapandia SB, Frisman DM, Hitchcock CL, Ellis GL, Popek EJ. Melanotic neuroectodermal tumor of infancy: clinicopathological, immunohistochemical, and flow cytometric study. Am J Surg Pathol. 1993;17(6):566–573.
